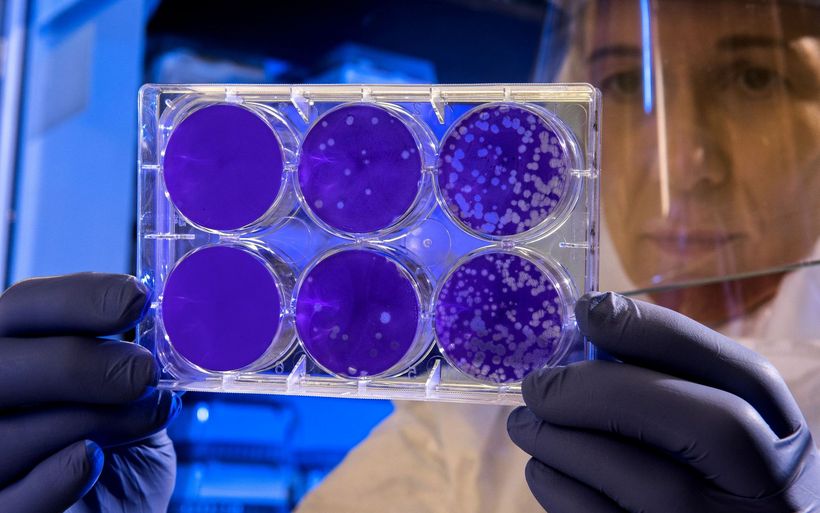

Laut den aktualisierten Angaben des Bundesamtes für Gesundheit (BAG) lagen bis am Dienstagabend 37 durch das Referenzlabor in Genf bestätigte Infektionen vor. Mehr als 2200 Personen mit Verdacht auf das neue Coronavirus seien bisher negativ abgeklärt worden.
Die erste Person, die im Kanton Genf positiv auf das Coronavirus getestet worden war, ist wieder gesund und hat das Spital verlassen können, wie das Departement für Sicherheit, Arbeit und Gesundheit (DSES) am Dienstag mitteilte.
Gleichzeitig meldete der Kanton Genf einen weiteren Fall einer Infektion mit dem Sars-CoV-2-Virus. Insgesamt seien vier erkrankte Patienten unter strenger medizinischer Aufsicht in Spitalpflege. Insgesamt 54 Personen im Kanton Genf befänden sich in präventiver Quarantäne.
Von Mailand in den WK
Erstmals wurde im Schweizer Militär ein Armeeangehöriger positiv auf das Coronavirus getestet. Der Mann befand sich auf dem Waffenplatz Wangen an der Aare BE, wie Armeesprecher Daniel Reist am Dienstag mitteilte. Der Patient ist auf der Krankenstation des Waffenplatzes isoliert worden.
Der Armeeangehörige sei am Montag zum Wiederholungskurs (WK) mit dem Militärpolizeibataillon 3 eingerückt. Bei der Eintrittsmusterung habe der Mann erklärt, dass er sich zuvor in Mailand aufgehalten habe. Ein erster Test durch das ABC Labor Spiez sei positiv ausgefallen. Die Bestätigung durch das Referenzlabor in Genf stehe noch aus.
Der Kanton Zug meldete derweil den ersten Coronavirus-Fall in der Zentralschweiz. Das Virus konnte bei einem 21-jährigen Mann nachgewiesen werden, der im Kanton wohnhaft ist. Er hatte sich an einem privaten Anlass im Kanton Zürich angesteckt. Da er sich seit mehreren Tagen im Kanton Zürich aufhält, wurde er in einem Zürcher Spital isoliert.
Im Kanton Aargau stieg die Zahl der Infizierten von zwei auf sechs Personen. Es handelt sich bei den Betroffenen um zwei Männer und zwei Frauen zwischen 30 und 63 Jahren. Die vier Personen haben sich teilweise im Ausland und teilweise in der Schweiz mit dem Coronavirus infiziert.
TI: neue Fälle und alte Schutzmasken
Im Tessin hat das Departement für Gesundheit und Soziales zwei weitere Fälle bestätigt. Damit sind im Südkanton aktuell drei Personen am Virus erkrankt. In beiden Fällen handle es sich um Frauen, wie das Departement für Gesundheit und Soziales mitteilte.
Eine von ihnen stand in engem Kontakt mit dem zweiten Coronavirus-Patienten des Kantons. Die andere habe sich vor kurzem in Norditalien aufgehalten.
Das medizinische Personal in Tessiner Spitälern, Arztpraxen und Altersheimen erhält neu Schutzmasken. Obwohl das Ablaufdatum der Schutzmasken teilweise überschritten sei, könnten dieses problemlos eingesetzt werden, hielt die Regierung in einer Mitteilung fest. Der Kantonsapotheker habe das Material geprüft und für sicher befunden.
Die neusten Entwicklungen in der Branche
Schweiz Tourismus und HotellerieSuisse informieren laufend über die neusten Vorkehrungen und Massnahmen in der Tourismusbranche:
Updates Schweiz Tourismus
Updates HotellerieSuisse
Neue Fälle auch in VD, VS und BE
Im Kanton Waadt gibt es einen zweiten, bestätigten Fall einer Ansteckung mit dem Coronavirus. Es handelt sich um einen 80-jährigen Mann, der im Universitätsspital von Lausanne (CHUV) behandelt wird, wie der kantonale Krisenstab und der Kantonsarzt mitteilten. Der Patient habe mit einer Person aus Italien in seinem Haus Kontakt gehabt.
Das Referenzlabor in Genf bestätigte weiter einen zweiten Fall im Kanton Wallis. Beide Patienten stammen aus der gleichen Familie und sind im Spital in Sitten isoliert, ihr Zustand sei gut, meldeten die Walliser Behörden.
Der Kanton Bern meldete einen vierten nachgewiesenen Fall. Der 22-Jährige war vor zwei Wochen in Mailand. Er ist zusammen mit seiner Freundin im Spital unter Quarantäne. Der Mann stammt aus dem Kanton Neuenburg und besuchte am Wochenende seine Freundin im Berner Oberland.
Veranstalter sprechen von «Berufsverbot»
Der Verband der Schweizer Konzert-, Show- und Festivalveranstalter (SMPA) hat am Dienstag scharfe Kritik an einem generellen Verbot von Veranstaltungen ab 1000 Personen geübt. In einer Medienmitteilung sprach er von einem «Berufsverbot». Der SMPA forderte eine finanzielle Entschädigung der Ausfälle über einen Krisenfonds.
Der Pharmazulieferer Lonza lässt seit Montag wegen des Coronavirus bei allen Grenzgängern aus Italien vor dem Zutritt zum Werk in Visp die Körpertemperatur messen, wie er am Dienstag einen Bericht des «Walliser Boten» bestätigte. Wer Fieber hat, wird aus Vorsicht umgehend nach Hause geschickt.
Am Dienstag wurde ebenfalls bekannt, dass Bundesrat Alain Berset am 9. März nicht an die Konferenz der Uno-Kommission zum Status der Frauen in New York reist. Die Organisatoren haben den Anlass wegen des Coronavirus stark zusammengestrichen und auf örtliche Organisationen begrenzt. Berset hätte am Montag eine Rede halten sollen.
NW verbietet Anlässe über 200 Personen
In Nidwalden liegt zwar noch keine bestätigte Infektion vor. Trotzdem hat die Regierung ab sofort private und öffentliche Veranstaltungen verboten, an denen sich gleichzeitig mehr als 200 Personen aufhalten. Der Kanton Luzern hat den Tag der Volksschulen vom 12. März abgesagt. Statt Einblicke in den Schul- und Unterrichtsalltag gibt es nun Unterricht nach Stundenplan.
Die für Mittwoch geplante Kundgebung gegen die Pensionskassenrevision des Freiburger Staatspersonals findet nun doch nicht statt. Erst wollte das Staatspersonal an der Protestaktion festhalten. Der Amtsstatthalter des Saane-Bezirks untersagte am Abend die Demonstration. (sda)
Weitere aktuelle Meldungen zum Thema: